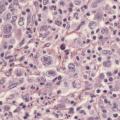

Lymphome hodgkinien classique
MALADIE DE HODGKIN
Image
Métastase cérébrale unique
CANCER DU POUMON
METASTASE
Image
Psoriasis vulgaire sur peau noire
PSORIASIS
Image
Piqûre par poisson-pierre
POISSON VENENEUX
MORSURES ET PIQURES
Image
Piqûre de vive
POISSON VENENEUX
VENIN
Image
Urticaire
URTICAIRE
Image
Hernie inguinale bilatérale
HERNIE INGUINALE
Image
Hernie contenant la vessie
HERNIE
Image
Hernie inguinale du garçon
HERNIE INGUINALE
Image
Dacryocystite chronique
DACRYOCYSTITE CHRONIQUE
Image
Leucoplasie
LEUCOPLASIE
Image
Kérato-acanthome sous-unguéal
KERATOACANTHOME
DOIGT
OSTEOLYSE
Image
Dermite du siège candidosique
CANDIDOSE
NOURRISSON
DERMITE DU SIEGE
Image
Héliodermie
HELIODERMIE
VIEILLISSEMENT PEAU
RAYONS UVA
Image
Langue plicaturée
LANGUE SCROTALE
Image
Kérato-acanthome sous-unguéal
KERATOACANTHOME
DOIGT
Image
Dermatopathie diabétique
COMPLICATIONS DU DIABETE
MALADIES DE LA PEAU
MEMBRES INFERIEURS
Image
Maladie de Behçet
MALADIE DE BEHCET
APHTOSE BUCCALE
LANGUE
Image
Chondrocalcinose du genou
CHONDROCALCINOSE
GENOU
Image
Héliodermie
HELIODERMIE
VIEILLISSEMENT PEAU
RAYONS UVA
Image
Masse au decours d'un Syndrome de Pancoast-Tobias
SYNDROME DE PANCOAST-TOBIAS
Image
Lymphome hodgkinien
MALADIE DE HODGKIN
HISTOLOGIE
Image
Hyperplasie folliculaire bénigne
LYMPHOMES
HISTOLOGIE
Image